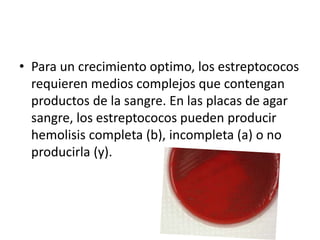
• Para un crecimiento optimo, los estreptococos
requieren medios complejos que contengan
productos de la sangre. En las placas de agar
sangre, los estreptococos pueden producir
hemolisis completa (b), incompleta (a) o no
producirla (y).
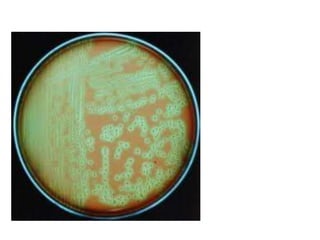
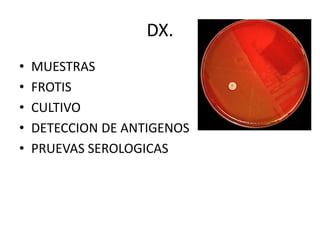
DX.
• MUESTRAS
• FROTIS
• CULTIVO
• DETECCION DE ANTIGENOS
• PRUEVAS SEROLOGICAS

Los estreptococos viridans son bacterias grampositivas que forman parte de la flora normal de las vías respiratorias altas. Se clasifican según su patrón de hemólisis, sustancia específica del grupo, polisacáridos capsulares y reacciones bioquímicas. Poseen varios antígenos como el de la pared celular, proteína M, sustancia T y ácido lipoteicoico que les permiten adherirse a células. Pueden secretar toxinas y enzimas como estreptocinasa, estreptodorn